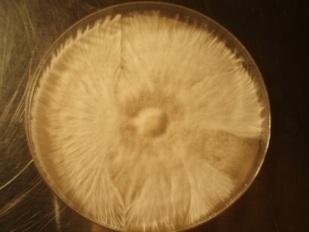

Selektionierung von Myzelsträngen
(Schwierigkeitsstufe 3 – Spezialist)
Auf Agarnährböden wachsendes Pilzmyzel kann recht verschiedenartig aussehen. Die beiden Hauptformen sind: rhizomorphes (wurzel-/strangähnliches) und 'fluffiges' (watteähnliches) Myzel. Für die weitere Kultivierung und die Bildung von Fruchtkörpern ist nur das rhizomorphe Myzel geeignet.
Betrachtet man rhizomorph wachsendes Myzel, erinnert seine Struktur und sein Aussehen an feine Wurzeln von Pflanzen. Aus diesem Myzel bilden sich später Primordia (kleine Köpfchen), aus denen später die Fruchtkörper wachsen. Werden Pilzkulturen auf Agarplatten in Petrischalen angelegt,
müssen fluffige Myzelstränge von den rhizomorph wachsenden getrennt werden. Die rhizomorphen Myzelstränge selektioniert und kultiviert man weiter.
Rhizomorphe und fluffige Myzelstränge auf einer Petrischale. Hier wurde das Myzel bereits 1 mal selektioniert.
Empfohlenes Zubehör:
- Haarnetz und Gesichtsmaske
- Latexhandschuhe
- Spiritusbrenner
- Skalpell mit sterilen Klingen
- Flächendesinfektionsmittel
- Handdesinfektionsmittel
- Agarplatten in Petrischalen
- Parafilm zum Versiegeln der Petrischalen
- Glove Bag (steriler Arbeitsraum)
Übertragen von rhizomorphen Myzelsträngen
Spätestens, wenn eine Agarplatte vollständig mit Myzel bewachsen ist, sollte diese selektioniert werden. Wenn man zu lange wartet, überwuchert das fluffige Myzel die rhizomorphen Stränge und die Petrischale wird unbrauchbar. Wie bei jedem Arbeitsschritt im Labor ist auch hier steriles, sauberes und schnelles Arbeiten eine Voraussetzung für den Erfolg. Vor Arbeitsbeginn die Hände, Unter- und Oberarme gründlich waschen und desinfizieren. Wir empfehlen das Tragen von Handschuhen, Mundschutz und Haarnetz und das Arbeiten in einer Impfbox/Glovebox oder vor einem HEPA-Filter (steriler Luftstrom).

Diese bewachsene Agarplatte ist nun bereit zum Selektionieren.
Werden mehrere Petrischalen in einem Arbeitsgang selektioniert, ist es wichtig, vor jeder neuen Kultur sowohl Hände als auch Arbeitsfläche zu desinfizieren. Handschuhe und Skalpellklinge bitte ebenfalls wechseln. Um ein möglichst keimfreies Arbeiten zu gewährleisten, empfiehlt es sich, den vorderen Abschnitt des Skalpellhalters kurz über einem Spiritusbrenner zum Glühen zu bringen. Bevor man die neue Klinge aufsetzt, um das Myzel zu bearbeiten, sollte der Skalpellgriff auf Zimmertemperatur abkühlen. Das Myzel darf nicht mit heißen Materialien in Berührung kommen.
Vorsicht: Einweghandschuhe und Desinfektionsmittel sind leicht entflammbar!
Aus der mit Myzel bewachsenen Agarplatte wählt man eine rhizomorph wachsende Stelle und schneidet mehrere etwa 3x3 mm große Stücke heraus.
Auf der Skalpellklinge soll nun je eines dieser Myzelstücke heraus gehoben und in eine neue Petrischale auf Agar-Nährboden gelegt werden.
Die fertig beimpften Petrischalen bitte sofort mit Parafilm versiegeln und nur vorsichtig bewegen, damit das aufgelegte Myzelstück nicht verrutscht.

Die Myzelstränge auf dieser Agarplatte in Petrischale werden zum ersten mal selektioniert,

hier wird bereits zum zweiten Mal selektioniert.
TIPP: Die Petrischale mit dem zu selektionierenden Myzel vor eine Lampe halten, um die rhizomorphen Stränge besser zu erkennen!
Wir empfehlen, von jedem Myzel gleich mehrere Agarplatten zu beimpfen. Auch unter besten Laborbedingungen muss mit Ausfällen von rund 10 % der selektionierten und überimpften Petrischalen gerechnet werden. Als Anfänger sollte man bei Ausfällen von 25% oder mehr nicht gleich den Mut verlieren. Das selektionierte Myzel kann auch mutieren (zum Beispiel wieder fluffig wachsen) und somit unbrauchbar werden.
Oft ist es notwendig, Pilzkulturen mehrmals zu selektionieren, bis man eine rhizomorph durchwachsene Petrischale erhält. Üblicherweise werden die Petrischalen mit Datum, Gattung, Strain und evtl. einer fortlaufenden Nummer beschriftet (Lackstifte oder CD-Marker halten gut auf der Oberfläche).


Die Myzelstücke werden auf die frischen Nährböden gelegt.
Myzelwachstum
Die fertig beimpften Agarplatten in Petrischalen werden für die Wachstumsphase des Myzels an einem sauberen, dunklen Ort bei der für die
jeweilige Pilzgattung empfohlenen Temperatur gelagert. Im Brutraum oder -kasten muss für ausreichend Frischluftzufuhr gesorgt werden.
Nach einigen Tagen bis zu einer Woche keimen die Sporen aus. Sobald das selbst gezüchtete Myzel auf der ganzen Agarplatte gleichmäßig
rhizomorph wächst, kann damit Körnerbrut beimpft werden.


Das Myzel muss so lange selektioniert werden, bis es gleichmäßig rhizomorph wächst.
Literaturnachweis:
„Mycelium running/ How mushrooms can help save the world“, Paul Stamets; Ten Speed Press, Berkeley/Toronto;
„The Mushroom Cultivator: A Practical Guide to Growing Mushrooms at Home", Paul Stamets, Agarikon Press; First Edition (December 1983);
„Growing Gourmet and Medicinal Mushrooms”, Paul Stamets, Ten Speed Press, Berkeley/Toronto;